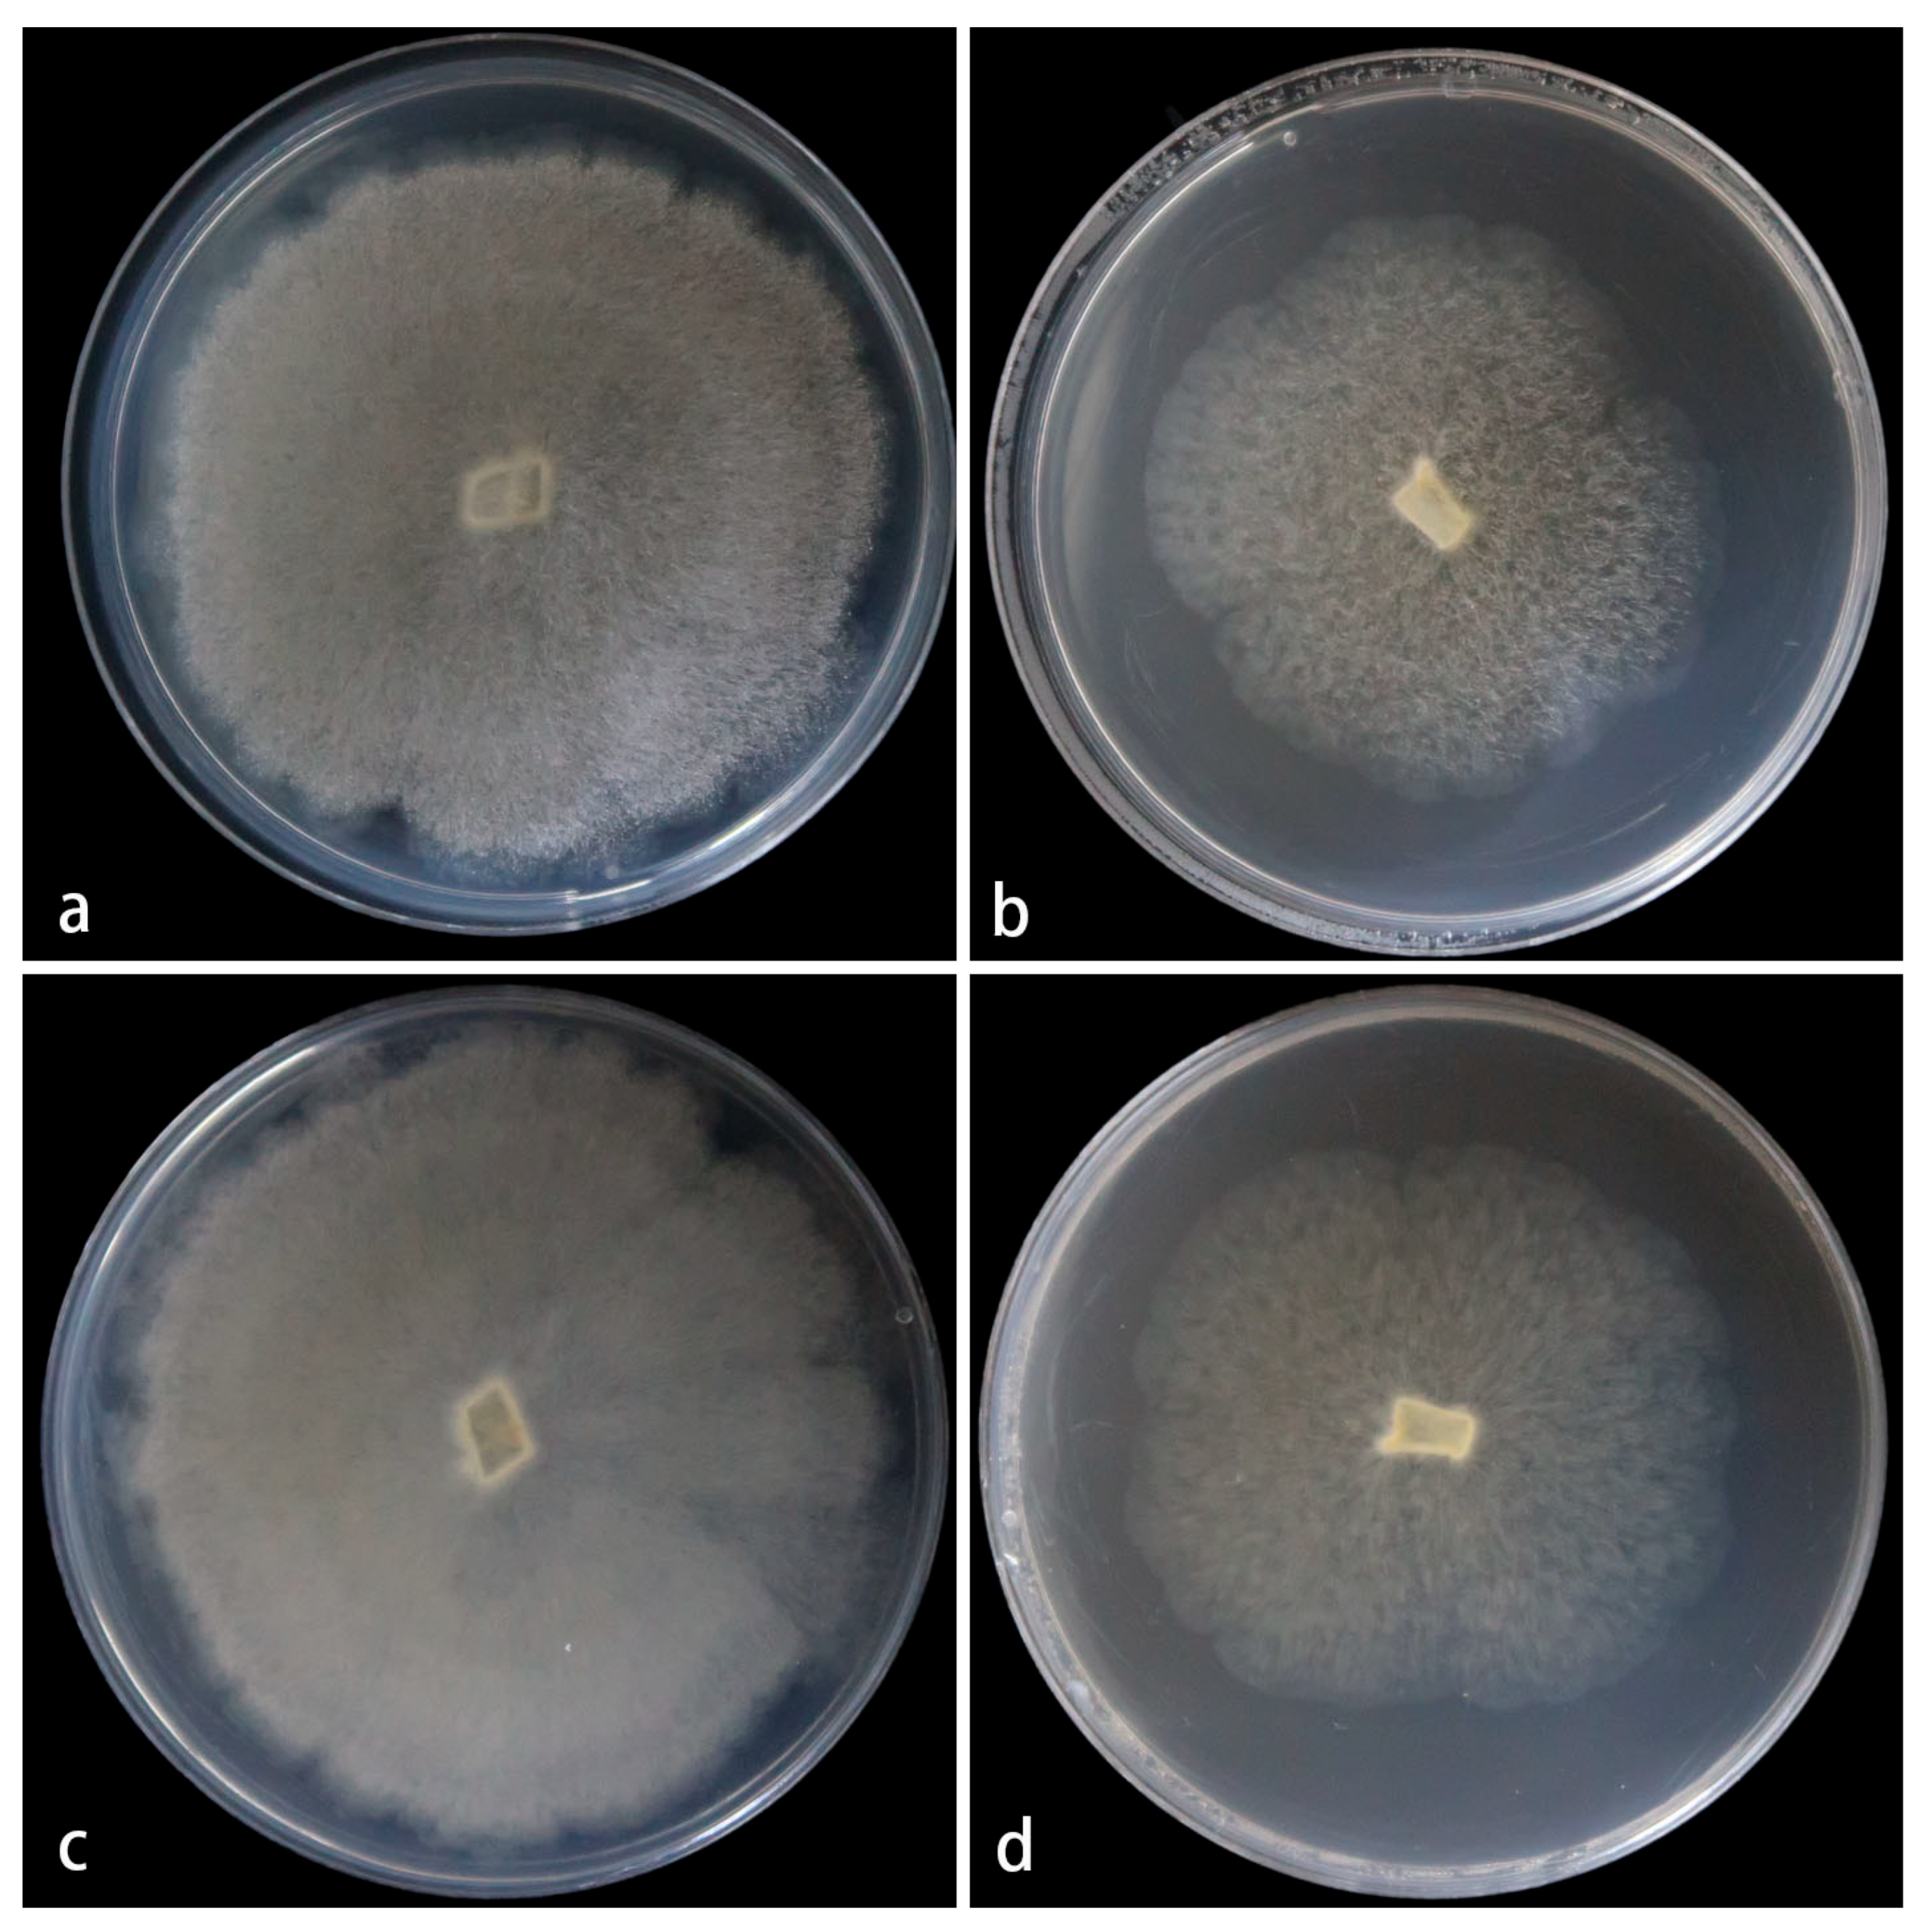
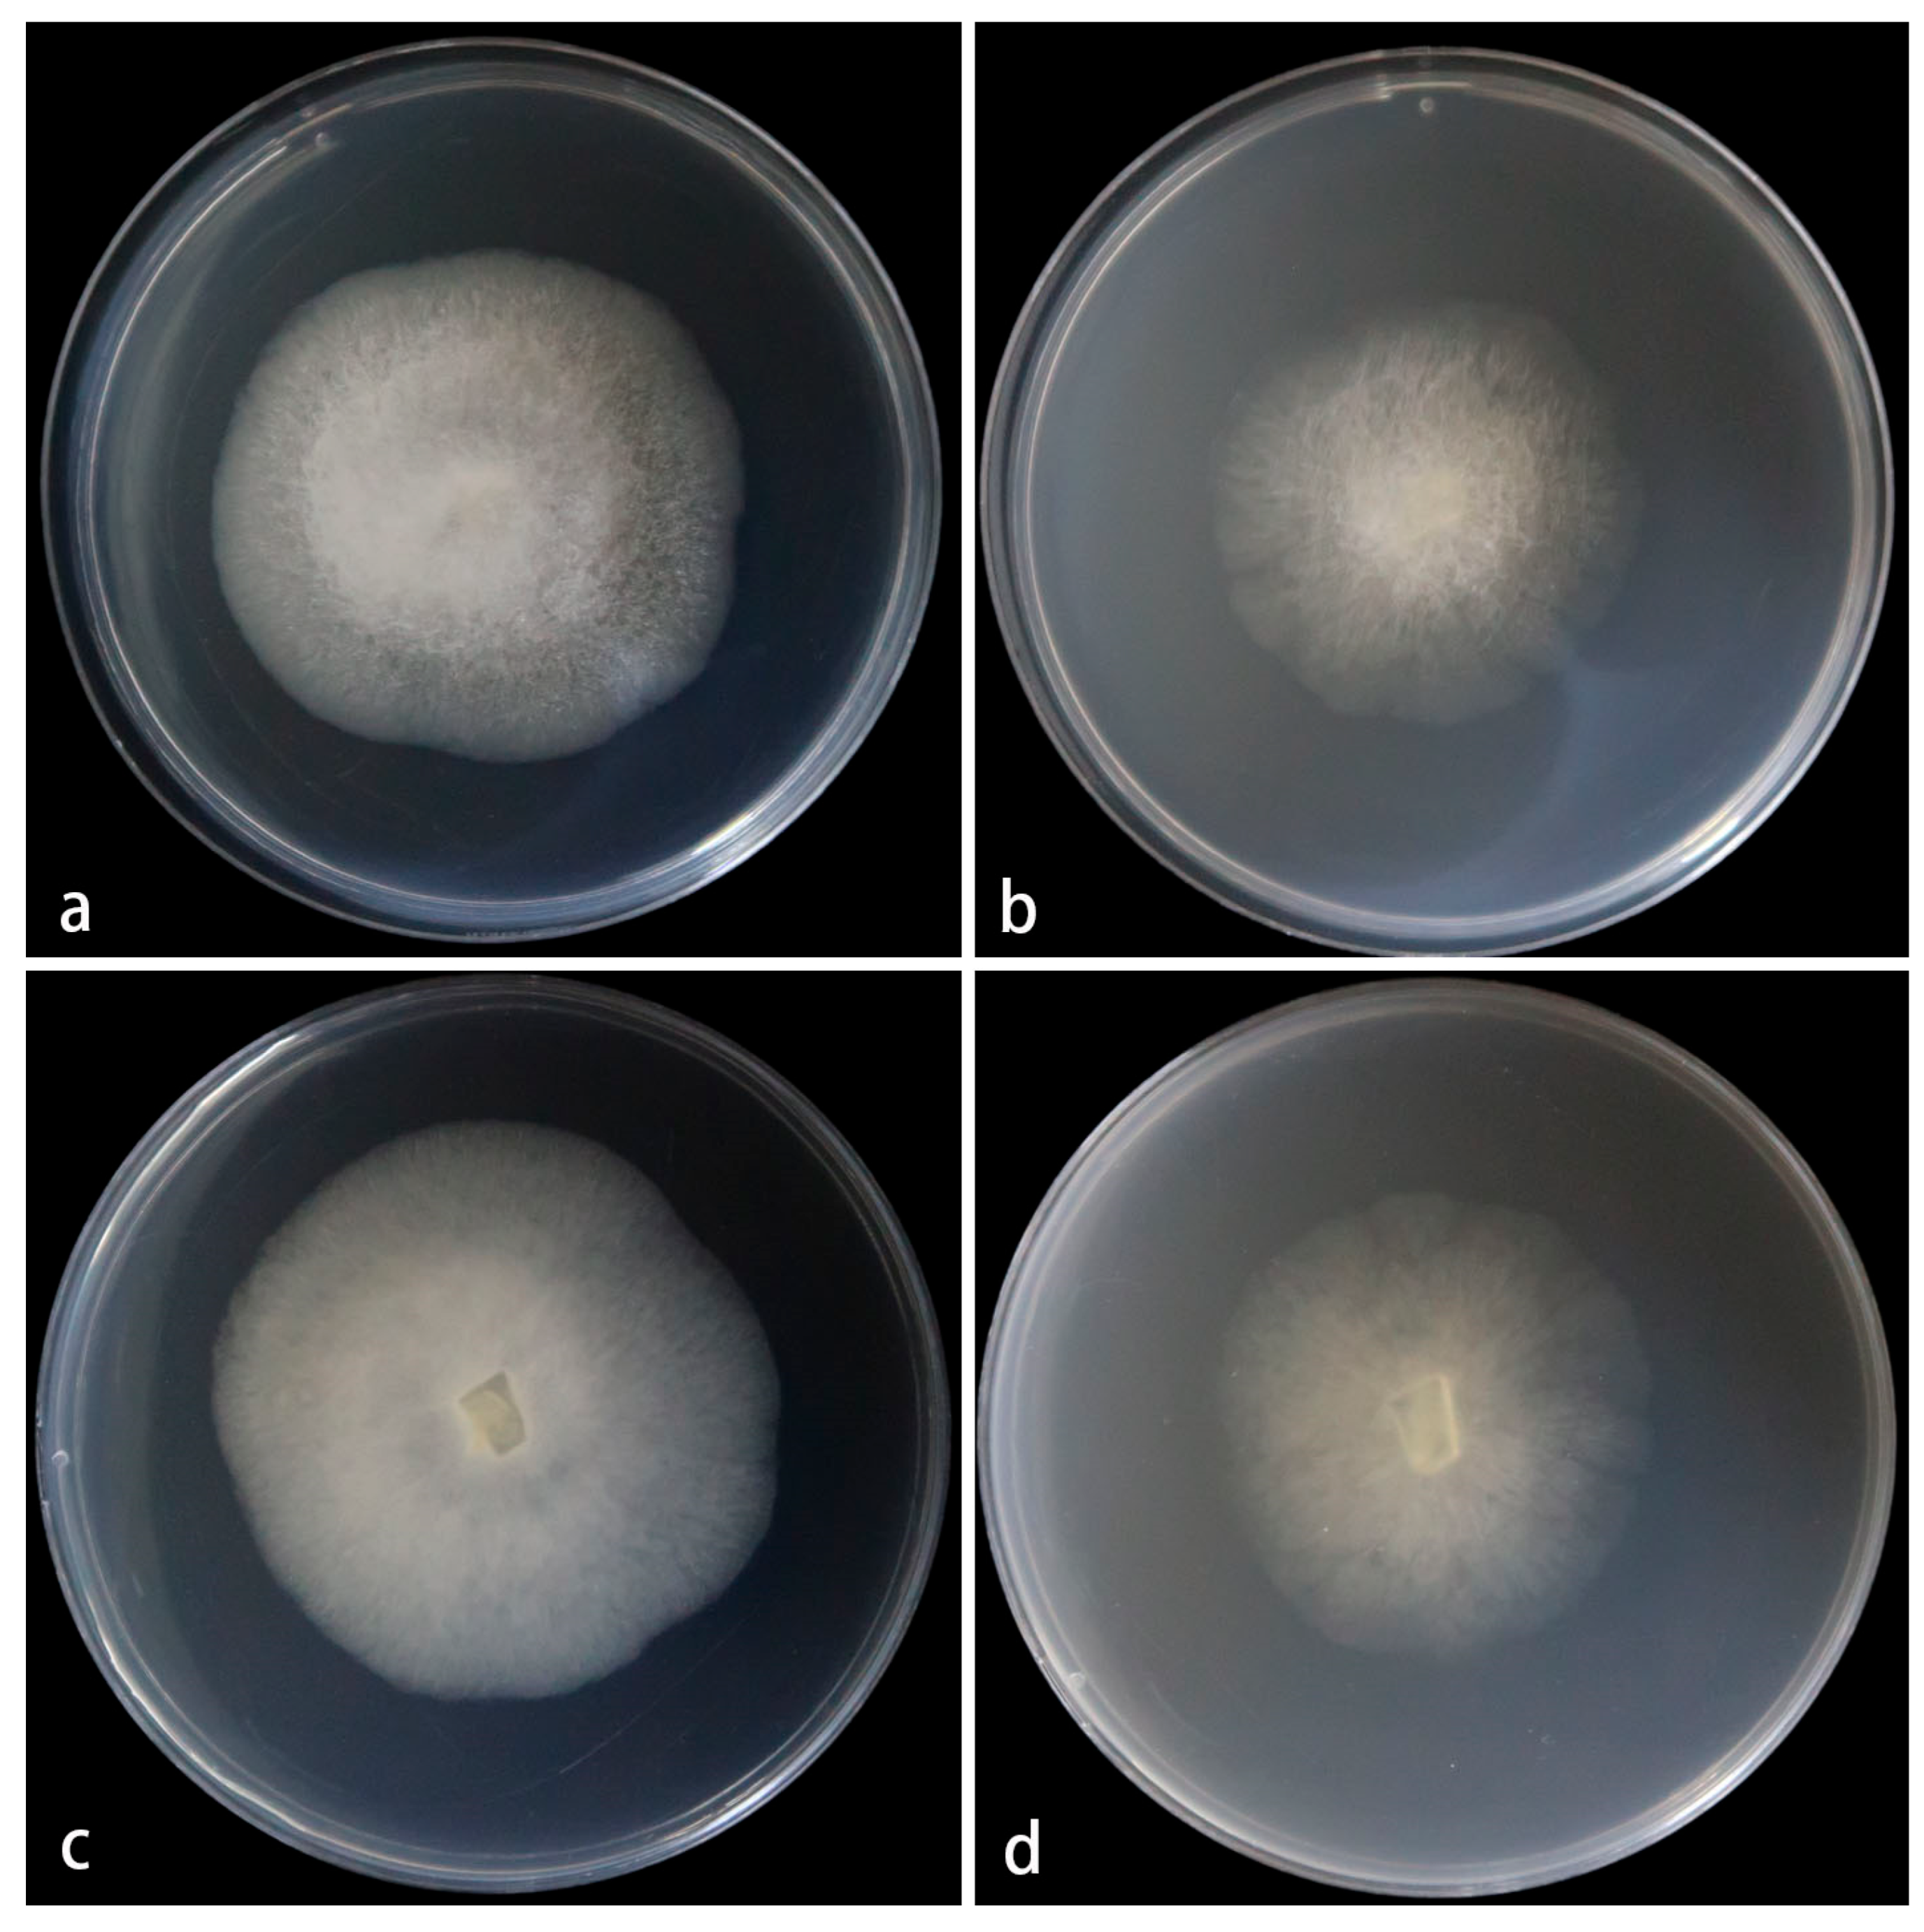
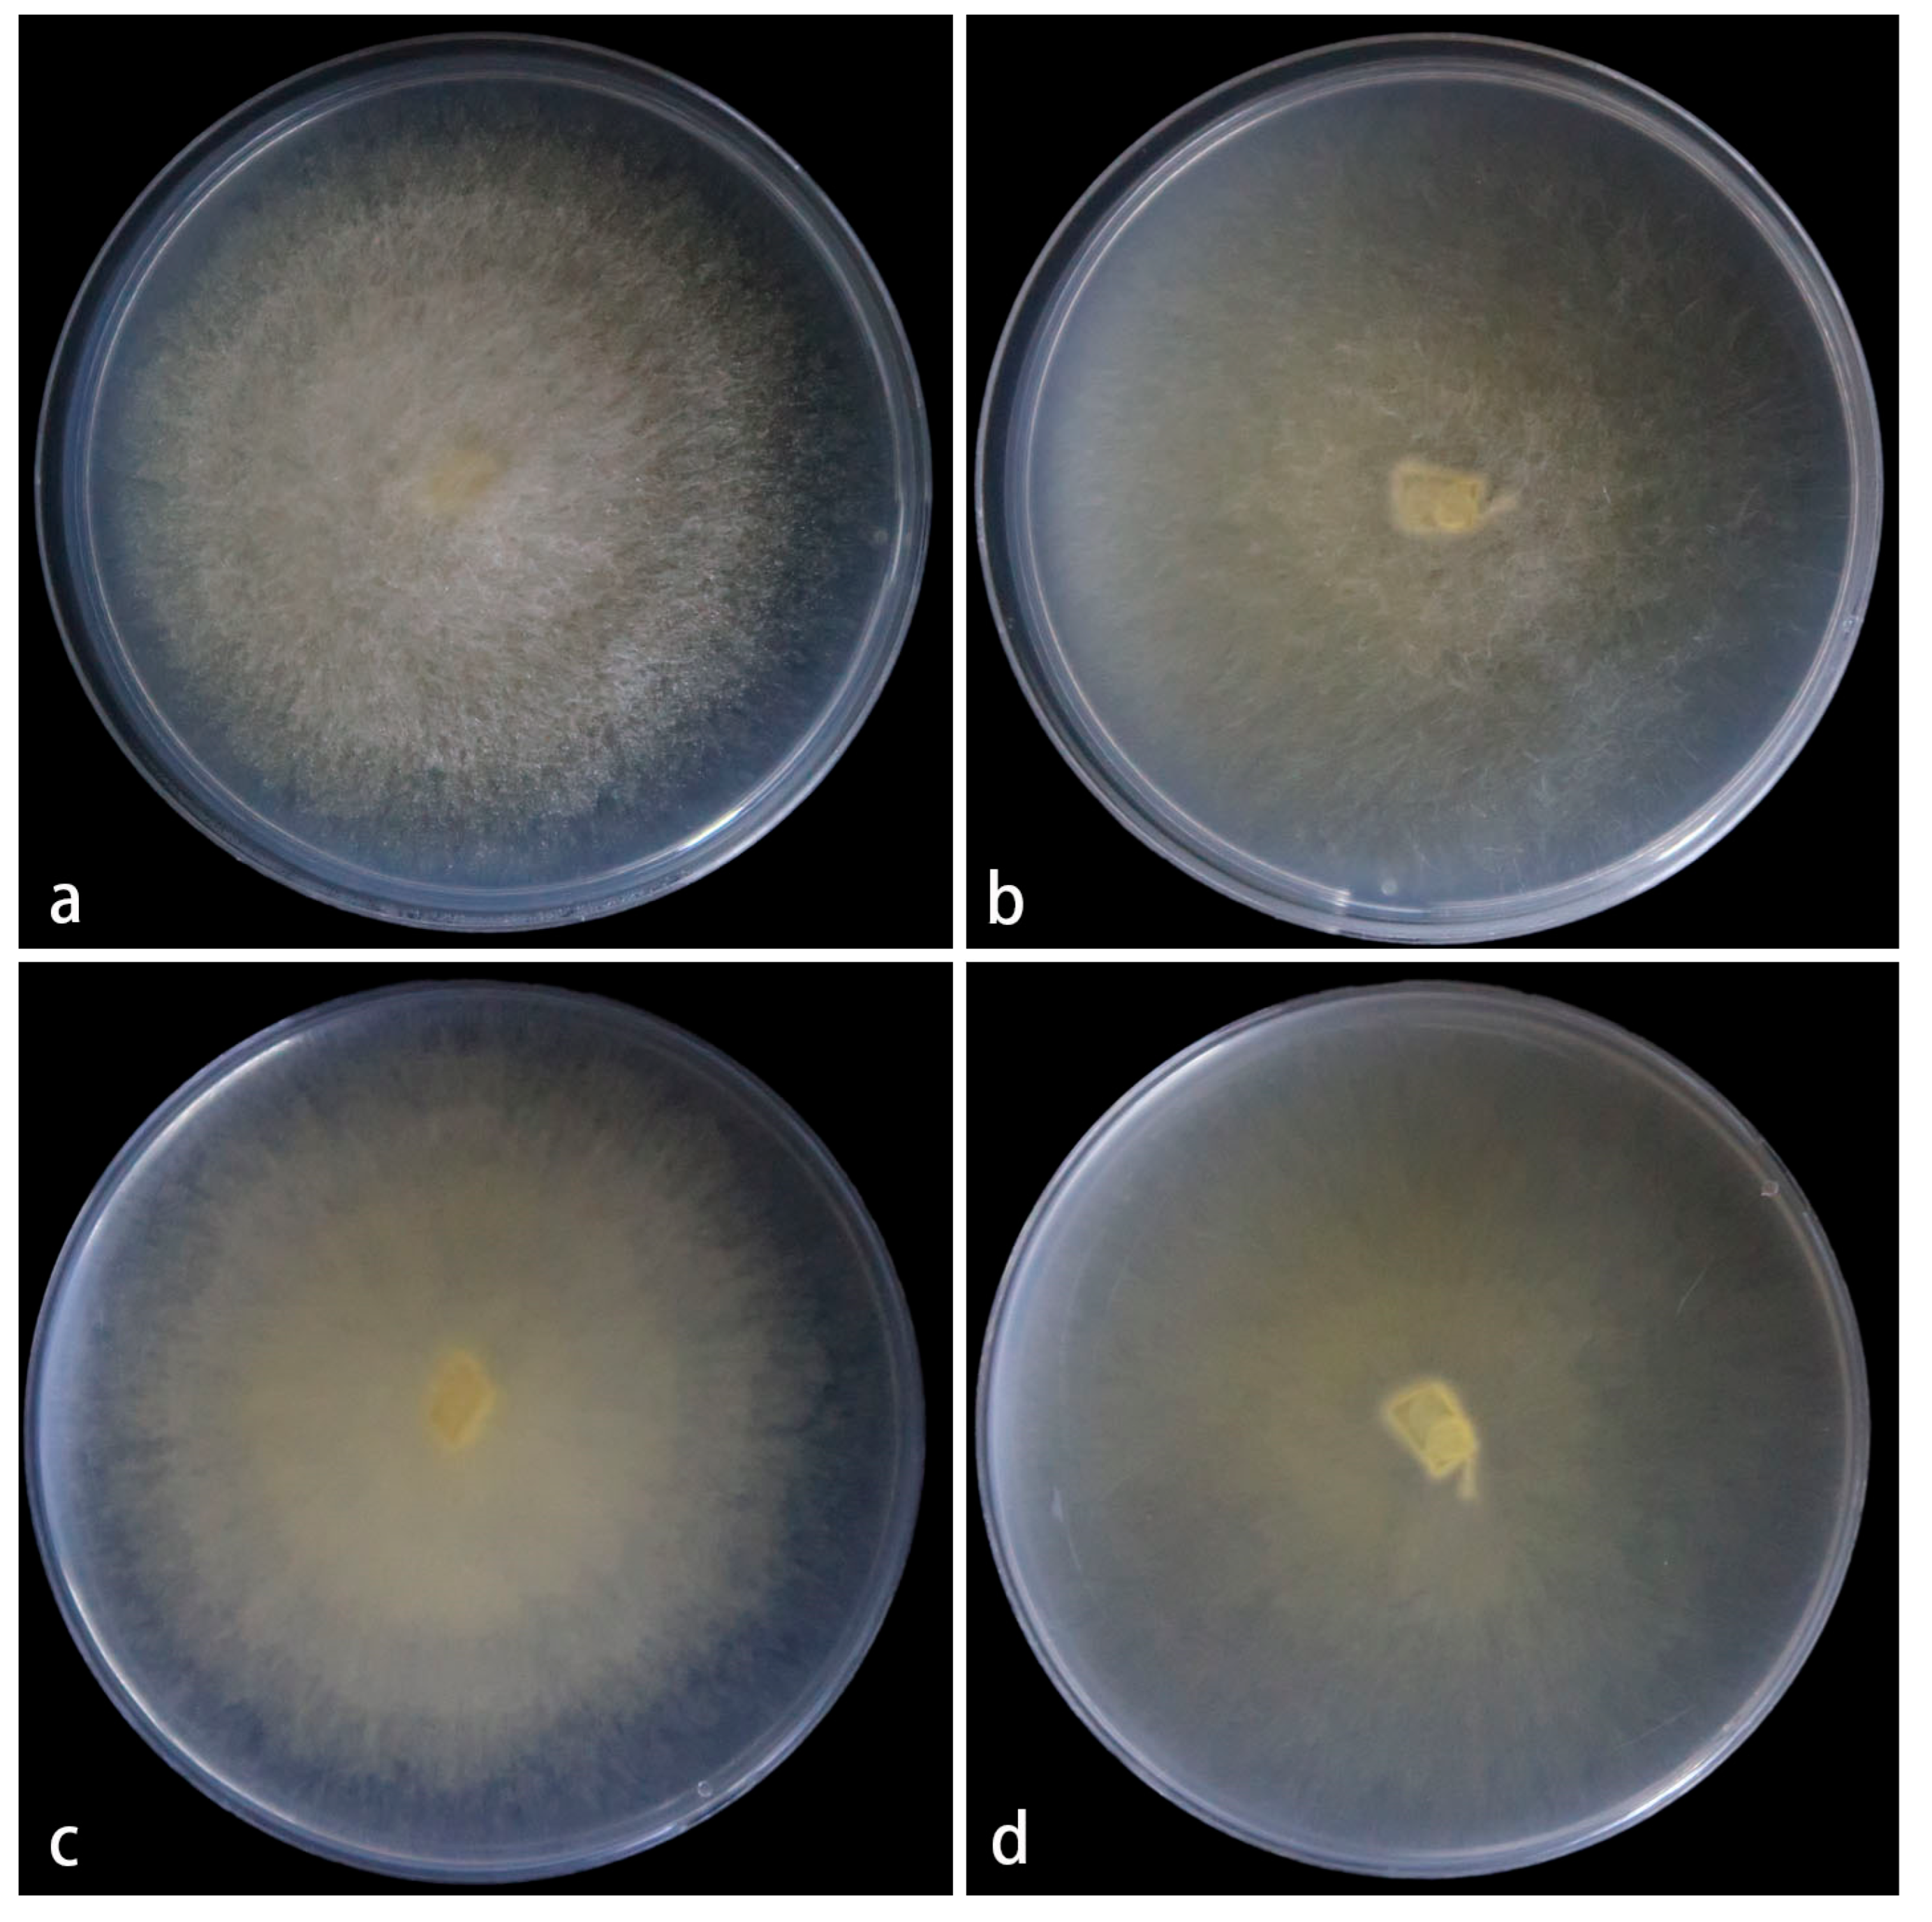
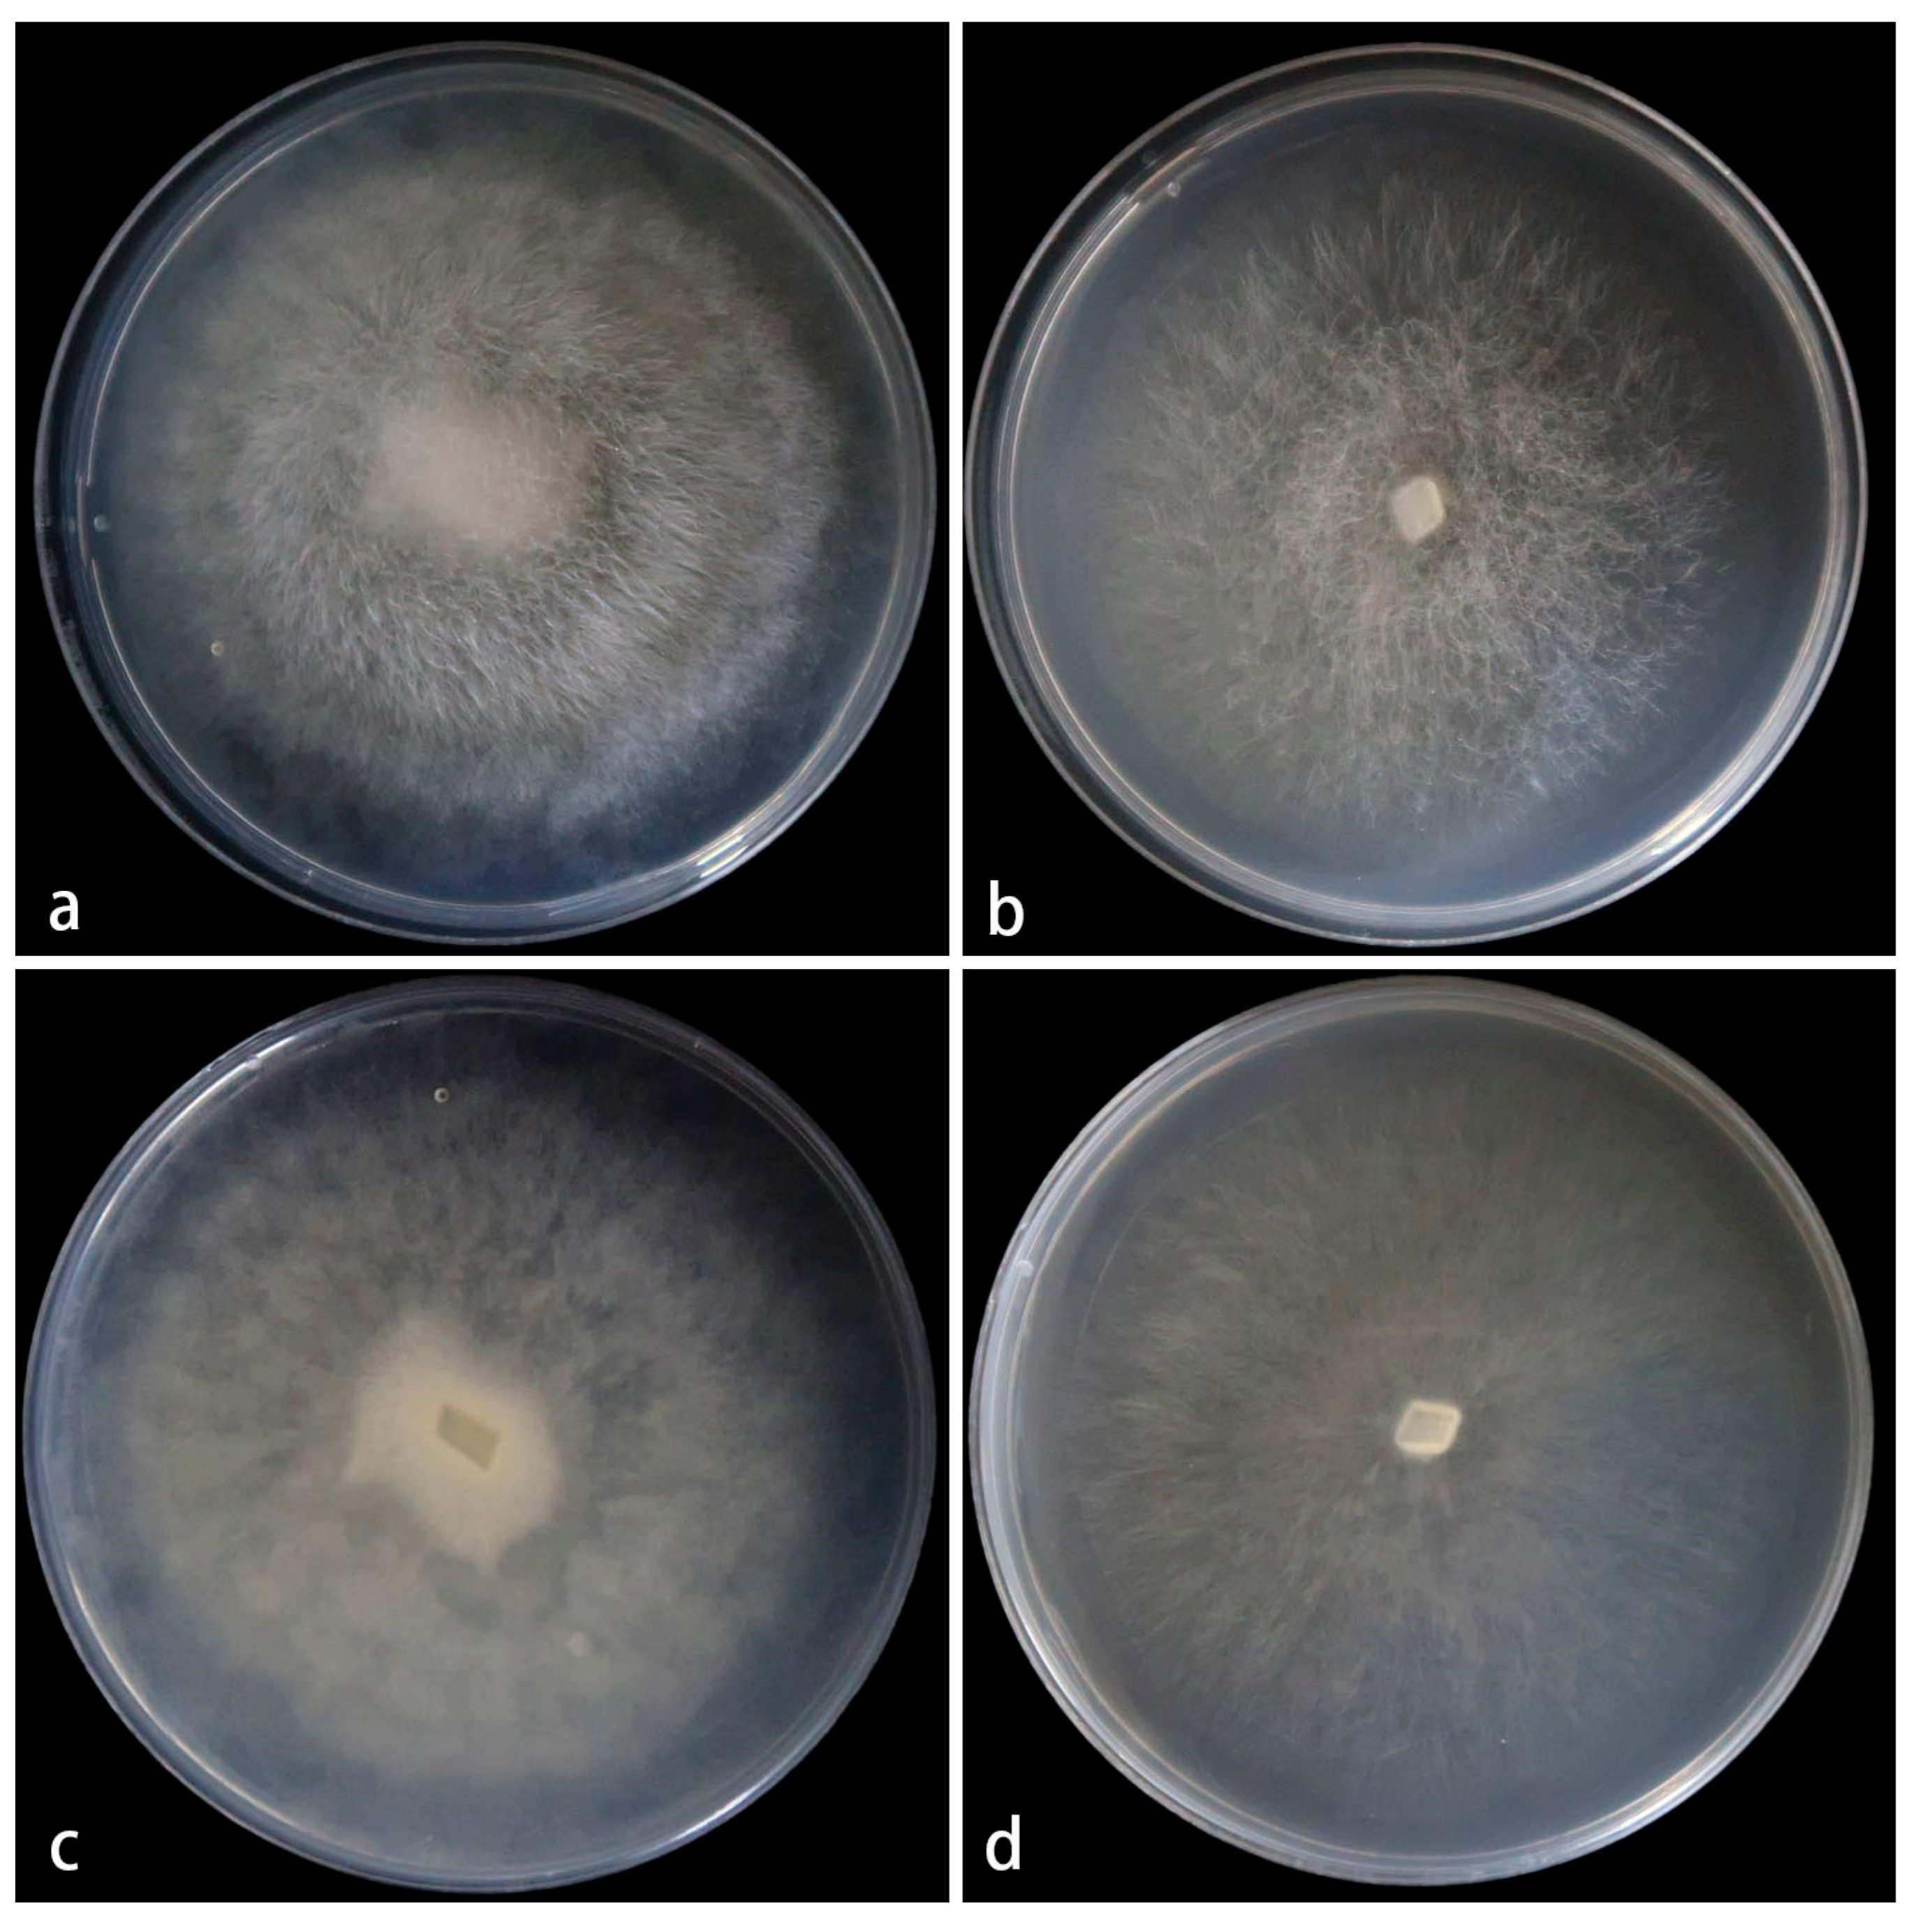

Unveiling Species Diversity Within Early-Diverging Fungi from China IX: Four New Species of Mucor (Mucoromycota)
Abstract
1. Introduction
2. Materials and Methods
2.1. Sample Collection and Strain Isolation
2.2. Morphology and Maximum Growth Temperature
2.3. DNA Extraction, PCR Amplification, and Sequencing
2.4. Phylogenetic Analyses
3. Results
3.1. Phylogeny
3.2. Taxonomy
3.2.1. Mucor globosporus Z.Y. Ding, H. Zhao & X.Y. Liu, sp. Nov., Figure 2

3.2.2. Mucor multimorphus Z.Y. Ding, H. Zhao & X.Y. Liu, sp. Nov., Figure 4

3.2.3. Mucor polymorphus Z.Y. Ding, H. Zhao & X.Y. Liu, sp. Nov., Figure 6

3.2.4. Mucor xizangensis Z.Y. Ding, H. Zhao & X.Y. Liu, sp. Nov., Figure 8

4. Morphological Comparison and Key to the Genus Mucor in China
- Zygospores known………………………………………………..……….M. homothallicusZygospores unknown…………………………………………………………………….....2
- Aborted sporangia known……………………………………………………………….....3Aborted sporangia unknown……………………………………………………………....6
- Fertile sporangia globose only………………………………………………….……..…...4Fertile sporangia globose and subglobose………………………………...……………...5
- Fertile sporangia 19.0–30.0 μm diameter……………………………M. abortisporangiumFertile sporangia 19.0–34.5 μm diameter………………………………………M. radiates
- Columellae 7.5–24.0 μm diameter…………………………………..…M. chlamydosporusColumellae 17.0–49.5 μm diameter……………………………….…….…… M. orientalis
- Collars known………………………………………………………………………………..7Collars unknown…………………………………………………………..……………….22
- Hyphae branched………………………………………………………….……..………….8Hyphae unbranched……………………………………………...…….…….………..…..19
- Sporangiospores shape > 2 kinds…………………………………………………..……...9Sporangiospores shape ≤ 2 kinds……………………………………………....………...10
- Fertile sporangia 17.0–52.5 μm diameter…………………………….……M. breviphorusFertile sporangia 33.8–70.0 μm diameter…………………………….…M. multimorphus
- Sporangiophores branched………………………………………….…………….…..….11Sporangiophores unbranched………………………………………………………...….14
- Sporangia > 65 μm diameter……………………………………………………………...12Sporangia < 65 μm diameter……………………………………………………………...13
- Sporangiospores 4.0–7.0 × 3.5–6.0 μm………………………………………...M. robustusSporangiospores 4.5–10.5 × 3.0–7.0μm…………………………….…..M. sinosaturninus
- Sporangiospores 4.0–7.0 × 3.0–5.0 μm…………………………………..M. changshaensisSporangiospores 3.5–5.5 × 2.5–3.5 μm……………………….…………...M. moniliformis
- Chlamydospores known……………………………………………………………….….15Chlamydospores unknown……………………………………………………………….18
- Sporangia > 38 μm diameter………………………………………………………...……16Sporangia < 38 μm diameter……………………………………………………...………17
- Columellaesubglobose, globose, ellipsoidal……………………………...M. globosporusColumellae hemispherical or depressed globose………………….....M. hemisphaericus
- Sporangiospores usually ellipsoid, occasionally reniform………..M. heilongjiangensisSporangiospores fusiform or ellipsoid……………………………….…....M. rhizosporus
- Collars obvious………………………………...……………………………M. amphisporusCollars not obvious………………………….…………………….…….M. fusiformisporus
- Chlamydospores known……………………………………………………………….....20Chlamydospores unknown……………………………………………………………….21
- Sporangiospores usually fusiform……………………………….……….M. polymorphusSporangiospores usually ellipsoidal……………………………………….M. xizangensis
- Columellae multiple shaped, with pyriform……………………….…………….M. tofusColumellae multiple shaped, without pyriform…………………..………M. brunneolus
- Chlamydospores known…………………………………………………………….…….23Chlamydospores unknown……………………………………………………………….26
- Fertile sporangia > 44 μm diameter………………………………………………..…….24Fertile sporangia < 44 μm diameter…………………………..…………........................25
- Columellae elongated-conical, cylindrical……………………………..M. chuxiongensisColumellae globose to subglobose………………………………………M. donglingensis
- Columellae hemispherical or depressed globose…………………………...M. floccosusColumellae conical to cylindrical………………………………………..M. hyalinosporus
- Sporangiophores unbranched……………………………………………….…..M. lobatusSporangiophores branched……………………………………….…………..…..M. rongii
5. Discussion
Supplementary Materials
Author Contributions
Funding
Institutional Review Board Statement
Informed Consent Statement
Data Availability Statement
Conflicts of Interest
References
- Nicolás, F.E.; Murcia, L.; Navarro, E.; Navarro-Mendoza, M.I.; Pérez-Arques, C.; Garre, V. Mucorales Species and Macrophages. J. Fungi 2020, 6, 94. [Google Scholar] [CrossRef]
- Spatafora, J.W.; Chang, Y.; Benny, G.L.; Lazarus, K.; Smith, M.E.; Berbee, M.L.; Bonito, G.; Corradi, N.; Grigoriev, I.; Gryganskyi, A.; et al. A phylum-level phylogenetic classification of zygomycete fungi based on genome-scale data. Mycologia 2016, 108, 1028–1046. [Google Scholar] [CrossRef]
- Pitt, J.I.; Hocking, A.D. Fungi and Food Spoilage; Springer: New York, NY, USA, 2009; pp. 151–157. [Google Scholar]
- Walther, G.; Pawłowska, J.; Alastruey-Izquierdo, A.; Wrzosek, M.; Rodriguez-Tudela, J.L.; Dolatabadi, S.; Chakrabarti, A.; de Hoog, G.S. DNA barcoding in Mucorales: An inventory of biodiversity. Persoonia 2013, 30, 11–47. [Google Scholar] [CrossRef] [PubMed]
- Nguyen, T.T.T.; Lee, H.B. Mucor cheongyangensis, a new species isolated from the surface of Lycorma delicatula in Korea. Phytotaxa 2020, 446, 33–42. [Google Scholar] [CrossRef]
- Boonmee, S.; Wanasinghe, D.N.; Calabon, M.S.; Huanraluek, N.; Chandrasiri, S.K.U.; Jones, G.E.B.; Rossi, W.; Leonardi, M.; Singh, S.K.; Rana, S.; et al. Fungal diversity notes 1387–1511: Taxonomic and phylogenetic contributions on genera and species of fungal taxa. Fungal Divers. 2021, 111, 1–335. [Google Scholar] [CrossRef]
- Lima, D.X.; De Azevedo Santiago, A.L.C.M.; De Souza-Motta, C.M. Diversity of Mucorales in natural and degraded semi-arid soils. Braz. J. Bot. 2016, 39, 1127–1133. [Google Scholar] [CrossRef]
- de Souza, C.A.F.; Lima, D.X.; Gurgel, L.M.S.; de Azevedo Santiago, A.L.C.M. Coprophilous Mucorales (ex Zygomycota) from three areas in the semi-arid of Pernambuco, Brazil. Braz. J. Microbiol. 2017, 48, 79–86. [Google Scholar] [CrossRef][Green Version]
- Ribes, J.A.; Vanover-Sams, C.L.; Baker, D.J. Zygomycetes in Human Disease. Clin. Microbiol. Rev. 2000, 13, 236–301. [Google Scholar] [CrossRef] [PubMed]
- Chandra, S.; Woodgyer, A. Primary cutaneous zygomycosis due to Mucor circinelloides. Australas. J. Dermatol. 2002, 43, 39–42. [Google Scholar] [CrossRef]
- Alvarez, E.; Cano, J.; Stchigel, A.M.; Sutton, D.A.; Fothergill, A.W.; Salas, V.; Rinaldi, M.G.; Guarro, J. Two new species of Mucor from clinical samples. Med. Mycol. 2011, 49, 62–72. [Google Scholar] [CrossRef]
- Nout, M.J.R.; Aidoo, K.E. Hofrichter, M., Ed.; Asian Fungal Fermented Food. In Industrial Applications; Springer: Berlin/Heidelberg, Germany, 2010; Volume 10, pp. 29–58. [Google Scholar] [CrossRef]
- Hermet, A.; Méheust, D.; Mounier, J.; Barbier, G.; Jany, J.L. Molecular systematics in the genus Mucor with special regards to species encountered in cheese. Fungal Biol. 2012, 116, 692–705. [Google Scholar] [CrossRef]
- Alves, M.H.; de Campos-Takaki, G.M.; Okada, K.; Ferreira-Pessoa, I.H.; Milanez, A.I. Detection of extracellular protease in Mucor species. Rev. Iberoam. Micol. 2005, 22, 114–117. [Google Scholar] [CrossRef]
- Roopesh, K.; Ramachandran, S.; Nampoothiri, K.M.; Szakacs, G.; Pandey, A. Comparison of phytase production on wheat bran and oilcakes in solid-state fermentation by Mucor racemosus. Bioresour. Technol. 2006, 97, 506–511. [Google Scholar] [CrossRef] [PubMed]
- Yazdi, M.T.; Zarrini, G.; Mohit, E.; Faramarzi, M.A.; Setayesh, N.; Sedighi, N.; Mohseni, F.A. Mucor hiemalis: A new source for uricase production. World J. Microbiol. Biotechnol. 2006, 22, 325–330. [Google Scholar] [CrossRef]
- de Carvalho, A.K.F.; Faria, E.; Rivaldi, J.D.; Andrade, G.S.S.; Oliveira, P.C.; de Castro, H.F. Performance of whole-cells lipase derived from Mucor circinelloides as a catalyst in the ethanolysis of non-edible vegetable oils under batch and continuous run conditions. Ind. Crops Prod. 2015, 67, 287–294. [Google Scholar] [CrossRef]
- de Souza, P.M.; de Assis Bittencourt, M.L.; Caprara, C.C.; de Freitas, M.; de Almeida, R.P.C.; Silveira, D.; Fonseca, Y.M.; Filho, E.X.F.; Junior, A.P.; Magalhães, P.O. A biotechnology perspective of fungal proteases. Braz. J. Microbiol. 2015, 46, 337–346. [Google Scholar] [CrossRef]
- Voigt, K.; Wolf, T.; Ochsenreiter, K.; Nagy, G.; Kaerger, K.; Shelest, E.; Papp, T. Hoffmeister, D., Ed.; 15 Genetic and metabolic aspects of primary and secondary metabolism of the Zygomycetes. In Biochemistry and Molecular Biology, 3rd ed.; Springer: Berlin, Germany, 2016; Volume III, pp. 361–385. [Google Scholar] [CrossRef]
- Morin-Sardin, S.; Nodet, P.; Coton, E.; Jany, J.L. Mucor: A Janus-faced fungal genus with human health impact and industrial applications. Fungal Biol. Rev. 2017, 33, 12–32. [Google Scholar] [CrossRef]
- Fresenius, G. Beiträge Zur Mykologie; Bei Heinrich Ludwig Brönner: Frankfurt, Germany, 1850; pp. 1–38. [Google Scholar]
- Benny, G.L.; Smith, M.E.; Kirk, P.M.; Tretter, E.D.; White, M.M. Li, D.W., Ed.; Challenges and Future Perspectives in the Systematics of Kickxellomycotina, Mortierellomycotina, Mucoromycotina, and Zoopagomycotina. In Biology of Microfungi (Fungal Biology); Springer: Cham, Switzerland, 2016. [Google Scholar] [CrossRef]
- Hurdeal, V.G.; Gentekaki, E.; Hyde, K.D.; Nguyen, T.T.T.; Lee, H.B. Novel Mucor species (Mucoromycetes, Mucoraceae) from northern Thailand. MycoKeys 2021, 84, 57–78. [Google Scholar] [CrossRef]
- Nguyen, T.T.T.; Jeon, Y.J.; Mun, H.Y.; Goh, J.; Chung, N.; Lee, H.B. Isolation and Characterization of Four Unrecorded Mucor Species in Korea. Mycobiology 2019, 48, 29–36. [Google Scholar] [CrossRef] [PubMed]
- Lima, D.X.; Barreto, R.W.; Lee, H.B.; Cordeiro, T.R.L.; de Souza, C.A.F.; de Oliveira, R.J.V.; Santiago, A.L.C.M. Novel Mucoralean Fungus from a Repugnant Substrate: Mucor merdophylus sp. nov., isolated from dog excrement. Curr. Microbiol. 2020, 77, 2642–2649. [Google Scholar] [CrossRef] [PubMed]
- Lima, C.L.F.; Lima, D.X.; de Souza, C.A.F.; de Oliveira, R.J.V.; Cavalcanti, I.B.; Gurgel, L.M.S.; Santiago, A. Description of Mucor pernambucoensis (Mucorales, mucoromycota), a new species isolated from the Brazilian upland rainforest. Phytotaxa 2018, 350, 274. [Google Scholar] [CrossRef]
- Zhao, H.; Nie, Y.; Zong, T.; Wang, K.; Lv, M.; Cui, Y.; Tohtirjap, A.; Chen, J.; Zhao, C.; Wu, F.; et al. Species diversity, updated classification and divergence times of the phylum Mucoromycota. Fungal Divers. 2023, 123, 49–157. [Google Scholar] [CrossRef]
- Walther, G.; Wagner, L.; Kurzai, O. Updates on the Taxonomy of Mucorales with an Emphasis on Clinically Important Taxa. J. Fungi 2019, 5, 106. [Google Scholar] [CrossRef]
- Ferroni, G.D.; Kaminski, J.S. Psychrophiles, psychrotrophs, and mesophiles in an environment which experiences seasonal temperature fluctuations. Can. J. Microbiol. 1980, 26, 1184–1190. [Google Scholar] [CrossRef]
- Sandle, T.; Skinner, K. Study of psychrophilic and psychrotolerant micro-organisms isolated in cold rooms used for pharmaceutical processing. J. Appl. Microbiol. 2013, 114, 1166–1174. [Google Scholar] [CrossRef]
- Linnaeus, C. Species Plantarum; Laurentius Salvius: Stockholm, Sweden, 1753; 1200p. [Google Scholar]
- Wijayawardene, N.N.; Pawłowska, J.; Letcher, P.M.; Kirk, P.M.; Humber, R.A.; Schüßler, A.; Wrzosek, M.; Muszewska, A.; Okrasinka, A.; Istel, L.; et al. Notes for genera: Basal clades of Fungi (including Aphelidiomycota, Basidiobolomycota, Blastocladiomycota, Calcarisporiellomycota, Caulochytriomycota, Chytridiomycota, Entomophthoromycota, Glomeromycota, Kickxellomycota, Monoblepharomycota, Mortierellomycota, Mucoromycota, Neocallimastigomycota, Olpidiomycota, Rozellomycota and Zoopagomycota). Fungal Divers. 2018, 92, 43–129. [Google Scholar] [CrossRef]
- Nguyen, T.T.T.; Lee, H.B. Discovery of Three New Mucor Species Associated with Cricket Insects in Korea. J. Fungi 2022, 8, 601. [Google Scholar] [CrossRef]
- Li, N.; Bowling, J.; de Hoog, S.; Aneke, C.I.; Youn, J.; Shahegh, S.; Cuellar-Rodriguez, J.; Kanakry, C.G.; Rodriguez Pena, M.; Ahmed, S.A.; et al. Mucor germinans, a novel dimorphic species resembling Paracoccidioides in a clinical sample: Questions on ecological strategy. mBio 2024, 15, e00144-24. [Google Scholar] [CrossRef] [PubMed]
- Nguyen, T.T.T.; de Santiago, A.L.C.M.A.; Hallsworth, J.E.; Cordeiro, T.R.L.; Voigt, K.; Kirk, P.M.; Crous, P.W.; Júnior, M.A.M.; Elsztein, C.; Lee, H.B. New Mucorales from opposite ends of the world. Stud. Mycol. 2024, 109, 273–321. [Google Scholar] [CrossRef]
- Zhao, H.; Nie, Y.; Huang, B.; Liu, X.Y. Unveiling species diversity within early-diverging fungi from China I: Three new species of Backusella (Backusellaceae, Mucoromycota). MycoKeys 2024, 109, 285–304. [Google Scholar] [CrossRef]
- Tao, M.F.; Ding, Z.Y.; Wang, Y.X.; Zhang, Z.X.; Zhao, H.; Meng, Z.; Liu, X.Y. Unveiling species diversity within early-diverging fungi from China II: Three new species of Absidia (Cunninghamellaceae, Mucoromycota) from Hainan Province. MycoKeys 2024, 110, 255–272. [Google Scholar] [CrossRef]
- Wang, Y.X.; Zhao, H.; Jiang, Y.; Liu, X.Y.; Tao, M.F.; Liu, X.Y. Unveiling species diversity within early-diverging fungi from China III: Six new species and a new record of Gongronella. (Cunninghamellaceae, Mucoromycota). MycoKeys 2024, 110, 287–317. [Google Scholar] [CrossRef]
- Ding, Z.Y.; Ji, X.Y.; Tao, M.F.; Jiang, Y.; Liu, W.X.; Wang, Y.X.; Meng, Z.; Liu, X.Y. Unveiling species diversity within early-diverging fungi from China IV: Four new species of Absidia (Cunninghamellaceae, Mucoromycota). MycoKeys 2025, 119, 29–46. [Google Scholar] [CrossRef] [PubMed]
- Ji, X.Y.; Ding, Z.Y.; Nie, Y.; Zhao, H.; Wang, S.; Huang, B.; Liu, X.Y. Unveiling species diversity: Within early-diverging fungi from China V: Five new species of Absidia (Cunninghamellaceae, Mucoromycota). MycoKeys 2025, 117, 267–288. [Google Scholar] [CrossRef] [PubMed]
- Wang, Y.X.; Ding, Z.Y.; Ji, X.Y.; Meng, Z.; Liu, X.Y. Unveiling species diversity within early-diverging fungi from China VI: Four Absidia sp. nov. (Mucorales) in Guizhou and Hainan. Microorganisms 2025, 13, 1315. [Google Scholar] [CrossRef] [PubMed]
- Ding, Z.Y.; Tao, M.F.; Ji, X.Y.; Jiang, Y.; Wang, Y.X.; Liu, W.X.; Wang, S.; Liu, X.Y. Unveiling species diversity within early-diverging fungi from China VII: Seven new species of Cunninghamella (Mucoromycota). J. Fungi 2025, 11, 417. [Google Scholar] [CrossRef]
- Ji, X.Y.; Jiang, Y.; Li, F.; Ding, Z.Y.; Meng, Z.; Liu, X.Y. Unveiling species diversity within early-diverging fungi from China VIII: Four new species in Mortierellaceae (Mortierellomycota). Microorganisms 2025, 13, 1330. [Google Scholar] [CrossRef]
- Li, W.X.; Wei, Y.H.; Zou, Y.; Liu, P.; Li, Z.; Gontcharov, A.A.; Stephenson, S.L.; Wang, Q.; Zhang, S.H.; Li, Y. Dictyostelid cellular slime molds from the Russian Far East. Protist 2020, 171, 125756. [Google Scholar] [CrossRef]
- Zou, Y.; Hou, J.G.; Guo, S.N.; Li, C.T.; Li, Z.; Stephenson, S.L.; Pavlov, I.N.; Liu, P.; Li, Y. Diversity of dictyostelid cellular slime molds, including two species new to science, in forest soils of Changbai Mountain, China. Microbiol. Spectr. 2022, 10, 02402–02422. [Google Scholar] [CrossRef]
- Corry, J.E.L. Rose bengal chloramphenicol (RBC) agar. In Progress in Industrial Microbiology; Elsevier: Amsterdam, The Netherlands, 1995; pp. 431–433. [Google Scholar]
- Zheng, R.Y.; Chen, G.Q.; Huang, H.; Liu, X.Y. A monograph of Rhizopus. Sydowia 2007, 59, 273–372. [Google Scholar]
- Zheng, R.Y.; Liu, X.Y.; Li, R.Y. More Rhizomucor causing human mucormycosis from China: R. chlamydosporus sp. nov. Sydowia 2009, 61, 135–147. [Google Scholar]
- Zong, T.K.; Zhao, H.; Liu, X.Y.; Ren, L.Y.; Zhao, C.L.; Liu, X.Y. Taxonomy and phylogeny of the Absidia (Cunninghamellaceae, Mucorales) introducing nine new species and two new combinations from China. Res. Sq. 2021. [Google Scholar] [CrossRef]
- Guo, L.D.; Hyde, K.D.; Liew, E.C.Y. Identification of endophytic fungi from Livistona chinensis based on morphology and rDNA sequences. New Phytol. 2000, 147, 617–630. [Google Scholar] [CrossRef] [PubMed]
- White, T.J.; Bruns, T.D.; Lee, S.B.; Taylor, J.W.; Innis, M.A.; Gelfand, D.H.; Sninsky, J. Amplification and direct sequencing of fungal ribosomal RNA genes for phylogenetics. In PCR Protocols: A Guide to Methods and Applications; Academic Press: New York, NY, USA, 1990; pp. 315–322. [Google Scholar]
- Vilgalys, R.; Hester, M. Rapid genetic identification and mapping of enzymatically amplified ribosomal DNA from several Cryptococcus species. J. Bacteriol. 1990, 172, 4238–4246. [Google Scholar] [CrossRef]
- Stiller, J.W.; Hall, B.D. The origin of red algae: Implications for plastid evolution. Proc. Natl. Acad. Sci. USA 1997, 94, 4520–4525. [Google Scholar] [CrossRef]
- Nylander, J. MrModeltest V2. program distributed by the author. Bioinformatics 2004, 24, 581–583. [Google Scholar] [CrossRef]
- Stamatakis, A. RAxML Version 8: A tool for phylogenetic analysis and post-analysis of large phylogenies. Bioinformatics 2014, 30, 1312–1313. [Google Scholar] [CrossRef] [PubMed]
- Huelsenbeck, J.P.; Ronquist, F. MRBAYES: Bayesian inference of phylogenetic trees. Bioinformatics 2001, 17, 754–755. [Google Scholar] [CrossRef] [PubMed]
- Madden, A.A.; Stchigel, A.M.; Guarro, J.; Sutton, D.; Starks, P.T. Mucor nidicola sp. nov., a fungal species isolated from an invasive paper wasp nest. Int. J. Syst. Evol. Microbiol. 2011, 62, 1710–1714. [Google Scholar] [CrossRef]
- Chai, C.Y.; Liu, W.J.; Cheng, H.; Hui, F.L. Mucor chuxiongensis sp. nov., a novel fungal species isolated from rotten wood. Int. J. Syst. Evol. Microbiol. 2019, 69, 1881–1889. [Google Scholar] [CrossRef]
- Bai, F.R.; Yao, S.; Cai, C.S.; Zhang, T.C.; Wang, Y.; Liu, W.; Ma, B.W.; Rong, C.Y.; Cheng, C. Mucor rongii sp. nov., a new cold-tolerant species from China. Curr. Microbiol. 2021, 78, 2464–2469. [Google Scholar] [CrossRef] [PubMed]
- Wang, Y.N.; Zheng, R.Y. Mucor tofus, a new species isolated from Mao-tofu (a fermented soybean food) in China. Phytotaxa 2022, 567, 233–244. [Google Scholar] [CrossRef]

| Loci | PCR Primers | Primer Sequence (5′–3′) | PCR Cycles | References |
|---|---|---|---|---|
| ITS | ITS5 ITS4 | GGA AGT AAA AGT CGT AAC AAG G TCC TCC GCT TAT TGA TAT GC | 95 °C 5 min; (95 °C 30 s, 55 °C 30 s, 72 °C 1 min) × 35 cycles; 72 °C 10 min | [51] |
| LSU | LR0R LR7 | GTA CCC GCT GAA CTT AAG C TAC TAC CAC CAA GAT CT | 95 °C 5 min; (95 °C 50 s, 47 °C 30 s, 72 °C 1.5 min) × 35 cycles; 72 °C 10 min | [52] |
| RPB1 | RPB-Af RPB-Cr | GAR TGY CCD GGD CAY TTY GG CCN GCD ATN TCR TTR TCC ATR TA | 95 °C 3 min; (94 °C 40 s, 60 °C 40 s, 72 °C 2 min) × 37 cycles; 72 °C 10 min | [53] |
| Species | Colonies | Sporangiophores | Sporangia | Columellae | Sporangiospores | Chlamydospores | Reference |
|---|---|---|---|---|---|---|---|
| M. globosporus | PDA: 25 °C 3 d, 59 mm, 19.7 mm/d, initially white, gradually becoming black-brown, floccose | unbranched, hyaline, 4.8–14.3 µm wide | globose, pale yellow to light brown, 16.6–76.1 μm diam. | 1.2–5.8 µm long | mostly spherical, 7.3–14 × 7.8–13.4µm, with or without spines, 0.7–1.9 µm long | globose, 6.6–11.3× 6.6–11.2 µm | This study |
| M. multimorphus | PDA: 25 °C 9 d, 77 mm, 8.56 mm/d, initially white, gradually becoming cream yellow, floccose | unbranched, 5.0–15.8 µm wide | globose, pale yellow to pale brown, 33.8–70.0 μm diam. | globose, ellipsoidal, pyriform, 10.1–40.0 × 7.5–39.7 µm | mainly fusiform and ellipsoidal, occasionally irregular, 5.4–18.0 × 3.3–7.8 µm | ellipsoidal or irregular, 6.3–16.8 × 8.1–12.5 µm | This study |
| M. polymorphus | PDA: 25 °C 3 d, 69 mm, 23 mm/d, initially white, gradually becoming yellowish-brown, floccose | occasionally branched, 2.2–14.4 µm wide | globose, pale yellow to light brown, 36.7–49.0 μm diam. | globose, ovoid, ellipsoidal, smooth-walled, 5.1–28.3 × 5.8–24.1 µm | fusiform, 3.7–7.0 × 1.9–3.6 µm | in chains, globose, ovoid, cylindrical or irregular, 4.5–17.2 × 3.9–13.9 µm | This study |
| M. xizangensis | PDA: 25 °C 5 d, 80 mm, 16 mm/d, initially white, gradually becoming grayish-white, floccose | unbranched, 5.0–17.8 µm wide | globose, white to light grayish-brown, 23.3–58.6 μm diam. | globose, ellipsoidal, ovoid, pyriform, 7.9–30.1 × 7.7–29.4 µm | usually ellipsoidal, 3.9–8.4 × 2.4–4.9 µm | mainly globose, 4.0–11.1 × 3.9–10.7 µm | This study |
| M. moniliformis | PDA: 27 °C 5 d, 90 mm, 10 mm high, floccose, granulate, initially white soon becoming buff-yellow, reverse irregular at margin | simply branched, somewhere slightly constricted, 6.0–13.5 μm wide | globose, light brown or dark brown when old, 18.0–64.5 μm diam. | subglobose and globose, 15.0–30.5 × 17.0–32.0 μm | ovoid, hyaline or subhyaline, 3.5–5.5 × 2.5–3.5 μm | in chains, ellipsoidal, ovoid, subglobose, globose or irregular, 5.5–17.0 × 7.0–15.5 μm | [27] |
Disclaimer/Publisher’s Note: The statements, opinions and data contained in all publications are solely those of the individual author(s) and contributor(s) and not of MDPI and/or the editor(s). MDPI and/or the editor(s) disclaim responsibility for any injury to people or property resulting from any ideas, methods, instructions or products referred to in the content. |
© 2025 by the authors. Licensee MDPI, Basel, Switzerland. This article is an open access article distributed under the terms and conditions of the Creative Commons Attribution (CC BY) license (https://creativecommons.org/licenses/by/4.0/).
Share and Cite
Ding, Z.-Y.; Ji, X.-Y.; Li, F.; Liu, W.-X.; Wang, S.; Zhao, H.; Liu, X.-Y. Unveiling Species Diversity Within Early-Diverging Fungi from China IX: Four New Species of Mucor (Mucoromycota). J. Fungi 2025, 11, 682. https://doi.org/10.3390/jof11090682
Ding Z-Y, Ji X-Y, Li F, Liu W-X, Wang S, Zhao H, Liu X-Y. Unveiling Species Diversity Within Early-Diverging Fungi from China IX: Four New Species of Mucor (Mucoromycota). Journal of Fungi. 2025; 11(9):682. https://doi.org/10.3390/jof11090682
Chicago/Turabian StyleDing, Zi-Ying, Xin-Yu Ji, Fei Li, Wen-Xiu Liu, Shi Wang, Heng Zhao, and Xiao-Yong Liu. 2025. "Unveiling Species Diversity Within Early-Diverging Fungi from China IX: Four New Species of Mucor (Mucoromycota)" Journal of Fungi 11, no. 9: 682. https://doi.org/10.3390/jof11090682
APA StyleDing, Z.-Y., Ji, X.-Y., Li, F., Liu, W.-X., Wang, S., Zhao, H., & Liu, X.-Y. (2025). Unveiling Species Diversity Within Early-Diverging Fungi from China IX: Four New Species of Mucor (Mucoromycota). Journal of Fungi, 11(9), 682. https://doi.org/10.3390/jof11090682

